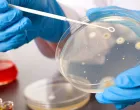
zdravstveno istraživanje/

Trideset i jedan novinar poginuo u izraelskim napadima na Jemen

Napad Izraela na Jemen/Stringer
CPJ navodi da je to drugi najsmrtonosniji pojedinačni napad na novinare ikada zabilježen i da su poginuli, iako su očigledno bili pripadnici vojnog krila Huta, trebali biti zaštićeni kao civili prema međunarodnom pravu.
Izraelski napadi na Jemen izvedeni su 10. septembra, nakon što je dron koji su lansirali Huti, koje podržava Iran, probio izraelsku višeslojnu protivzračnu odbranu i udario u aerodrom Ramon na jugu zemlje, pri čemu je jedna osoba ranjena.
Izraelske odbrambene snage (IDF) potom su izvele udare u Sani i oblasti El Džaf u Jemenu, nakon čega su saopćile da su pogođeni vojni kampovi Huta, mjesto okupljanja operativaca, sjedište propagandne divizije te militantne grupe i skladište goriva, dok su Huti izvijestili da je u udarima poginulo ukupno 35 ljudi.
Jemenske novine 26. septembar, koje se predstavljaju kao zvanično vojno glasilo Huta, imenovale su 31 novinara za koje su navele da su poginuli u izraelskim napadima. Tom prilikom pogođena je i njihova redakcija, kao i redakcija još jednog glasila pod kontrolom Huta – Jemen, koje su se nalazile u sjedištu Odjela za moralno vođenje vojske Huta u Sani.
CPJ je saopćio da ubistvo 31 novinara u Jemenu klasificira kao „namjerno ciljanje novinara zbog njihovog rada“, ali da za sada može potvrditi kako je devet od 31 poginulog zaista bilo novinara, piše Times of Israel.
Komisija za zaštitu novinara optužila je IDF da je odgovorna za ubistva jednog od šest novinara počinjena širom svijeta od 2016. godine, od kojih su mnogi ubijeni u Pojasu Gaze. IDF je saopćila da ne cilja namjerno novinare, te da su mnogi s CPJ-ove liste zapravo članovi palestinskih militantnih grupa.